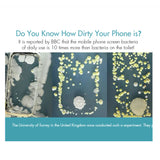
Mobile Phone UV Lamp Sterilizer Portable Smart Wireless Charging Cathode Ultraviolet Sterilization Disinfection white

Mobile Phone UV Lamp Sterilizer Portable Smart Wireless Charging Cathode Ultraviolet Sterilization Disinfection white
- Featuring cold cathode ultraviolet lamp that completely sanitize your entire phone to protect you and your family from harmful bacteria while you wait or charge overnight.(Notes: Only recognizes mobile phones with wireless charging function, can't disinfect metal or other objects.
- Multi-functional protection system providing overvoltage protection, temperature control, short-circuit prevention and more let you and your phone be safe and protected from any risk.
Description:
Product Category: UV Light Disinfector
Material: PC+ABS
Size: 110*100*100mm
- It also has two charging ports on the back of the device, a USB and USB-C. After plugging in, your device will automatically charge, disinfect and charge at the same time, or wirelessly charge.
- This wireless phone charger works with fully Qi-enabled devices like (for) iPhone X, XS, XS Max, iPhone XR, iPhone 8/8 Plus, Samsung Galaxy S10, S10 , S10E, Note 9, S9, S9 Plus and more.
- 6mm charging sensing distance, allowing you to charge with phone case(The thickness is less than 6mm and non-metalic); Besides, the wireless charger supports 5W ordinary and for Android 10W fast charge, you just need put your phone on it and it will match automatically.
Packing list:
1 X UV Light Disinfector (Phones not included)
Note:Light shooting and different displays may cause the color of the item in the picture a little different from the real thing. The measurement allowed error is +/- 1-3cm.
International rates apply when shipping to all other addresses outside the United States.
20298kiii-CVU-PEL_0FES64GP